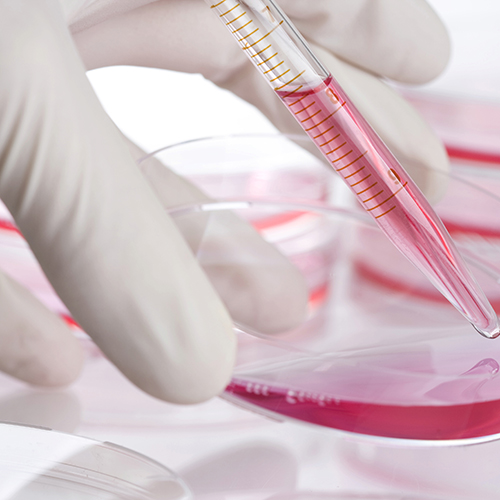

15 December 2022
Seven UniSA researchers have collectively been awarded $8 million by the National Health and Medical Research Council (NHMRC) to tackle some of the most serious health problems facing Australia.
Seven UniSA researchers have collectively been awarded $8 million by the National Health and Medical Research Council (NHMRC) to tackle some of the most serious health problems facing Australia.
Research projects starting in 2023 funded by NHMRC Ideas Grants will address medicine harm, chemotherapy side effects, brain tumours, pancreatic and blood cancers, melanoma, vascular disease, and miscarriages in pregnancy.
The successful researchers are:
Dr Renly Lim ($1.71 million): Co-designing a consumer-focused digital health system to improve adverse drug event (ADE) detection, management and reporting.
“Medicines have many benefits but can also cause harm,” Dr Lim says.
“Currently the effects of medicines and any potential harms are not monitored for most people taking medicines. This project will develop a new digital health system that enables consumers and health professionals to actively detect medicine harms, and to report the harms to the medicine regulatory authority in Australia. We will also develop new tools to better communicate medicine safety issues to the public.”
Professor Hamish Scott ($1.48 million): Genomic Autopsy of Pregnancy Loss Study (GAPS): genomic investigations to help solve unexplained pregnancy loss at all gestations.
“Despite scientific and medical advances, the rate of miscarriage and stillbirth has not declined in Australia over the past 20 years,” Prof Scott says.
“Our project aims to better understand the underlying causes of pregnancy loss across all gestations. We will use novel genomic techniques and, for the first time, study variations in the placenta that may contribute to pregnancy loss. Accurate diagnosis is essential for counselling and offers families reproductive choices to avoid future recurrence.”
Professor Angel Lopez ($1.28 million): Predicting disease progression in patients with myeloid neoplasms to enable early intervention.
“Myelodysplastic and myeloproliferative neoplasms (MDS/MPN) are blood cancers with multiple genetic mistakes that have a risk of progressing to acute myeloid leukaemia (AML), a rapid and fatal disease,” Prof Lopez says.
“There are no reliable approaches to predict who is going to develop AML. Based on the idea that a skewed hormone receptor is the cause of the problem we propose to identify its genetic fingerprint that can predict when MDS and MPN will transform to AML to enable faster and better treatments.”
Professor Claudine Bonder ($1.15 million): Targeting desmoglein-2 to reinvigorate anti-tumour immunity.
“Pancreatic cancer and melanoma are amongst the deadliest forms of cancer which are becoming more prevalent.” Prof Bonder says.
“Despite clinical advances, once metastasised, cancer from any organ is universally fatal. The growth and spread of solid tumours requires access to the blood supply as well as control of the immune response. Our work on tumour vasculature, in these difficult-to-treat tumours, has identified an adhesion protein on the cancer cells that may help fight this deadly disease.”
Professor Stuart Pitson ($844,149): New approaches to enhance immunotherapy for brain tumours.
“Primary brain tumours and brain metastases arising from other tumours both have extremely poor patient outcomes,” Prof Pitson says.
“Immunotherapy offers great promise for brain tumour therapy but is currently limited due to brain tumour-induced immunosuppression. This proposal aims to overcome this problem to improve the potency of brain tumour immunotherapies. Successful outcomes in this work have the potential to dramatically improve the survival outcomes for glioblastoma patients.”
Dr Andrea Stringer ($807,368): Protecting vitamin D levels to prevent chemotherapy-induced gastrointestinal mucositis.
“Vitamin D deficiency is common in cancer patients and is linked to the incidence of many cancers,” Dr Stringer says.
“Maintaining vitamin D levels is necessary to maximise therapeutic outcomes and preventing chemotherapy-induced mucositis. We will identify cancer patients who are ‘at risk’ for vitamin D deficiency, and then investigate therapeutic options for maintaining their vitamin D levels and preventing these side effects.”
Professor Natasha Harvey ($694,856): Investigating the application of targeted therapeutics for the treatment of complex lymphatic vascular anomalies.
“Complex lymphatic anomalies arise due to defects in the development of lymphatic vessels during embryogenesis, resulting in stillbirth or chronic disease,” Prof Harvey says.
“We have identified pathogenic variants in the MDFIC gene underlying a complex lymphatic anomaly termed CCLA. We will investigate the signalling pathways affected by pathogenic MDFIC variants and determine whether small molecule inhibitors of these signalling pathways might provide novel therapeutics able to effectively treat CCLA.”
The projects are led by researchers in UniSA Clinical and Health Sciences and in the Centre for Cancer Biology, an alliance between UniSA and SA Pathology, and will start in 2023, running for up to five years. They are among 232 projects collectively awarded $241 million NHMRC Ideas Grants.
Full details at: https://www.nhmrc.gov.au/funding/data-research/outcomes
Media contact: Candy Gibson M: +61 434 605 142 E: candy.gibson@unisa.edu.au




